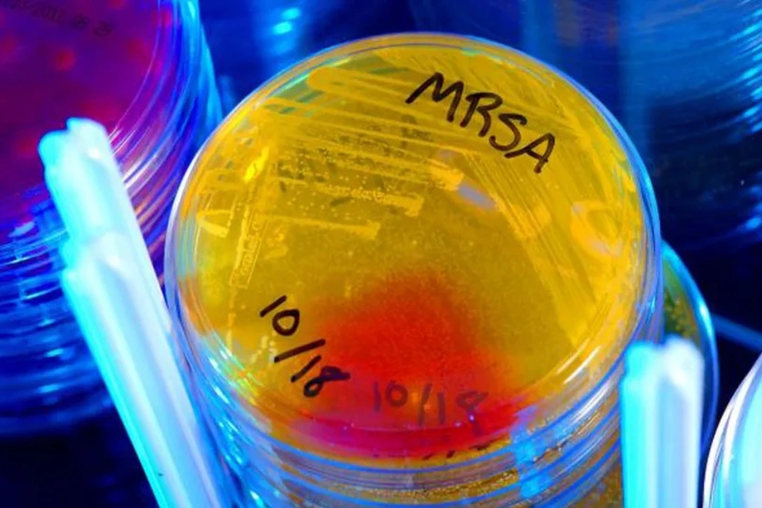
mrsa-khang-sinh.png

Làm sao tránh ngộ độc do ăn bánh mì? Chuyên gia Canada cảnh báo nguy cơ đại dịch cúm toàn cầu
Điểm tin ngày 11/11/2025, Doctor247 gửi đến bạn những tin tức mới nhất về lối sống và sức khỏe.
Làm sao tránh ngộ độc do ăn bánh mì?
Thời gian qua, nhiều vụ ngộ độc bánh mì tập thể đã xảy ra, với vụ mới nhất tại TP.HCM ghi nhận 235 ca tính đến ngày 10-11. Nguyên nhân chính thường do vi khuẩn Salmonella nhiễm chéo vào các nguyên liệu nhân bánh như patê, thịt, rau sống. Theo các chuyên gia, patê là môi trường giàu dinh dưỡng khiến vi khuẩn phát triển rất nhanh nếu quy trình chế biến, bảo quản không đảm bảo, đặc biệt khi thời tiết nắng nóng.

Ngộ độc Salmonella có thể dẫn đến biến chứng nặng như nhiễm khuẩn huyết, sốc nhiễm trùng, nhất là với người già và trẻ nhỏ. Để ngăn chặn, Cục An toàn thực phẩm (Bộ Y tế) đang xây dựng hướng dẫn kiểm soát đồng bộ cho thức ăn đường phố. Các chủ cơ sở kinh doanh nhấn mạnh việc phải siết chặt khâu nhập nguyên liệu, bảo quản đúng quy trình (dùng tủ lạnh, xe chuyên dụng) và tuyệt đối không dùng thực phẩm không rõ nguồn gốc.
Phát hiện kháng sinh mới mạnh gấp 100 lần, vi khuẩn không thể kháng lại
Các nhà khoa học vừa tình cờ phát hiện một hợp chất kháng sinh hoàn toàn mới từ vi khuẩn đất khi đang nghiên cứu một loại thuốc cũ. Hợp chất này, có tên pre-methylenomycin C lactone, cho thấy khả năng tiêu diệt hiệu quả các siêu vi khuẩn kháng thuốc "khó nhằn" như MRSA và Enterococcus faecium, vốn là nguyên nhân gây nhiễm trùng nặng tại bệnh viện.
Hợp chất mới này không chỉ mạnh hơn khoảng 100 lần so với kháng sinh gốc mà còn có một ưu điểm vượt trội: trong thử nghiệm kéo dài 28 ngày, vi khuẩn không thể phát triển khả năng kháng lại thuốc (lờn thuốc). Dù đây là một phát hiện đầy hứa hẹn, các nhà khoa học cho biết vẫn cần nhiều nghiên cứu để tổng hợp và đánh giá trước khi có thể phát triển thành thuốc điều trị cho người.
Giá vàng thế giới tăng vọt 115 USD do kỳ vọng Fed giảm lãi suất
Giá vàng thế giới đã tăng mạnh 115 USD trong phiên 10/11, lên mức 4.114 USD/ounce, cao nhất trong 2 tuần, và tiếp tục nhích lên 4.116 USD vào sáng 11/11. Nguyên nhân được cho là do các số liệu kinh tế Mỹ kém lạc quan, bao gồm báo cáo việc làm sụt giảm và niềm tin tiêu dùng lao dốc, làm dấy lên lo ngại về kinh tế.
Những dữ liệu này khiến thị trường đặt cược xác suất Cục Dự trữ liên bang Mỹ (Fed) giảm lãi suất vào tháng 12 đã tăng lên 64%. Giá vàng hưởng lợi trong môi trường lãi suất thấp và kinh tế bất ổn. Các kim loại quý khác như bạc, bạch kim và palladium cũng đồng loạt tăng giá theo sau vàng.
Lần đầu tiên khoa học chứng minh con người có "giác quan thứ 7"
Các nhà nghiên cứu tại Anh vừa phát hiện ra rằng con người sở hữu "giác quan thứ 7", một dạng "cảm ứng từ xa". Đây là khả năng cảm nhận được các vật thể bị chôn vùi trong cát mà không cần chạm trực tiếp vào chúng. Khám phá này là lần đầu tiên được quan sát thấy ở người, thách thức quan niệm truyền thống rằng xúc giác phải cần đến tiếp xúc vật lý.
Giác quan này được lấy cảm hứng từ các loài động vật như chim ven biển, vốn dùng cách cảm nhận rung động để tìm mồi. Phát hiện này mở ra tiềm năng phát triển các công nghệ hỗ trợ và chế tạo robot tiên tiến, có khả năng thực hiện các nhiệm vụ phức tạp như tìm kiếm khảo cổ hoặc khám phá địa hình dạng hạt trên sao Hỏa.
Chuyên gia Canada cảnh báo nguy cơ đại dịch cúm toàn cầu do chủng H3N2 đột biến
Các chuyên gia y tế Canada đang cảnh báo về nguy cơ bùng phát dịch cúm toàn cầu, trong bối cảnh số ca mắc gia tăng sớm và mạnh ở nhiều nơi. Australia ghi nhận số ca cao kỷ lục năm thứ hai liên tiếp, Anh có số ca cao gấp 3 lần năm ngoái, và Nhật Bản đã tuyên bố dịch cúm. Tác nhân chính được cho là chủng cúm A H3N2, vốn thường gây nhiễm trùng nặng.

Mối lo ngại lớn nhất là chủng H3N2 này đang cho thấy những thay đổi cấu trúc rõ rệt, khiến các chuyên gia lo ngại nó có thể đã "thích nghi" và khiến vaccine hiện có "không phù hợp". Các chuyên gia cảnh báo về khả năng xảy ra một đại dịch do virus đột biến này, trong khi Canada cũng đang đối mặt với mùa cúm khó khăn hơn cả năm 2024.
Vì sao Mỹ cấm phi công ngủ trong buồng lái trong khi châu Âu cho phép?
Cục Hàng không Liên bang Mỹ (FAA) nghiêm cấm phi công ngủ trong buồng lái suốt hành trình, ngay cả trên các chuyến bay dài. Quy định này hoàn toàn trái ngược với châu Âu, Canada và Australia, nơi cho phép hình thức "ngủ kiểm soát" (chợp mắt ngắn dưới 45 phút). Các cơ quan quốc tế này tin rằng việc nghỉ ngơi có kiểm soát giúp phi công tỉnh táo hơn khi hạ cánh.

FAA giữ lập trường cấm vì lo ngại việc này gây hiểu nhầm về an toàn, khó kiểm soát rủi ro, và do một vấn đề kỹ thuật trên Boeing 787 khiến ghế không thể ngả sâu.
Tuy nhiên, nhiều chuyên gia và hiệp hội phi công Mỹ cho rằng quy định này đã lỗi thời, vì mệt mỏi sinh học là mối đe dọa thực tế và một giấc ngủ ngắn được kiểm soát sẽ an toàn hơn là để phi công phải gắng sức chống lại cơn buồn ngủ.